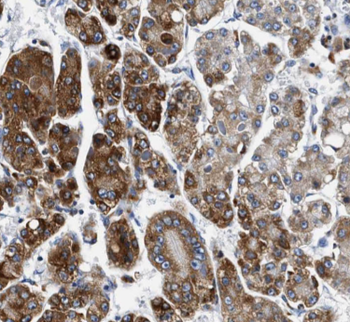
产品细节图片3

相关产品推荐更多 >
万千商家帮你免费找货
0 人在求购买到急需产品
- 详细信息
- 文献和实验
- 技术资料
- 抗体名:
GLA Antibody抗体
- 抗体英文名:
GLA Antibody
- 靶点:
GLA
- 应用范围:
ELISA, IHC, IP, WB
- 宿主:
Rabbit
- 适应物种:
Human, Mouse, Rat
- 保质期:
6-12个月
- 抗原来源:
详询
- 目录编号:
orb394691
- 级别:
科研级
- 库存:
88
- 供应商:
biorbyt
- 标记物:
Unconjugated
- 克隆性:
Polyclonal
- 形态:
liquid
- 亚型:
IgG
- 免疫原:
galactosidase, alpha
- 规格:
50 ug
别名:Alpha galactosidase A, galactosidase, alpha
免疫原:galactosidase, alpha
分子量:49 kDa
应用稀释比例:WB: 1:500-1:5000; IHC: 1:20-1:200; IP: 1:500-1:5000
纯度:≥95% as determined by SDS-PAGE
纯化:Immunogen affinity purified
保存说明:Maintain refrigerated at 2-8°C for up to 2 weeks. For long term storage store at -20°C in small aliquots to prevent freeze-thaw cycles.
UniProt ID:P06280
Note:For research use only.

风险提示:丁香通仅作为第三方平台,为商家信息发布提供平台空间。用户咨询产品时请注意保护个人信息及财产安全,合理判断,谨慎选购商品,商家和用户对交易行为负责。对于医疗器械类产品,请先查证核实企业经营资质和医疗器械产品注册证情况。
文献和实验tianjiaoya 我想构建一个真核表达质粒,用这个真核表达质粒来表达绿色荧光蛋白,但是我想让绿色荧光蛋白的表达受酵母菌GLA4转录因子的调控,也就是说有GLA4存在,这个质粒就表达绿色荧光蛋白,没有GLA4存在,就不表达绿色荧光蛋白。当然需要对真核表达质粒上的启动子做相应的调整,但是我现在的问题是,转录因子GLA4能不能对质粒上有相应调控元件的表达盒,进行调控?据说GLA4上有核定位元件,要是将这个核定位序列删除,可行吗?据说核内有很多的辅助因子,参与了蛋白
上海西唐生物科技有限公司 021-55229872, 65333639 www.westang.com 人 基质Gla 蛋白 (MGP)ELISA 试剂盒 ( 用于血清、血浆、细胞培养上清液和唾液等其它生物体液内 ) 原理 本实验采用双抗体夹心 ABC-ELISA 法。用抗人 MGP 单抗包被于酶标板上,标准品和样品中的 MGP与单抗结合,加入生物素化的抗人
The vitamin K-dependent coagulation plasma proteins possess from 9 to 12 residues of γ-carboxyglutamic acid (Gla) distributed in an approx 40 amino acid peptide sequence, that is, the Gla domain, which encompasses the N-terminal region
技术资料暂无技术资料 索取技术资料










